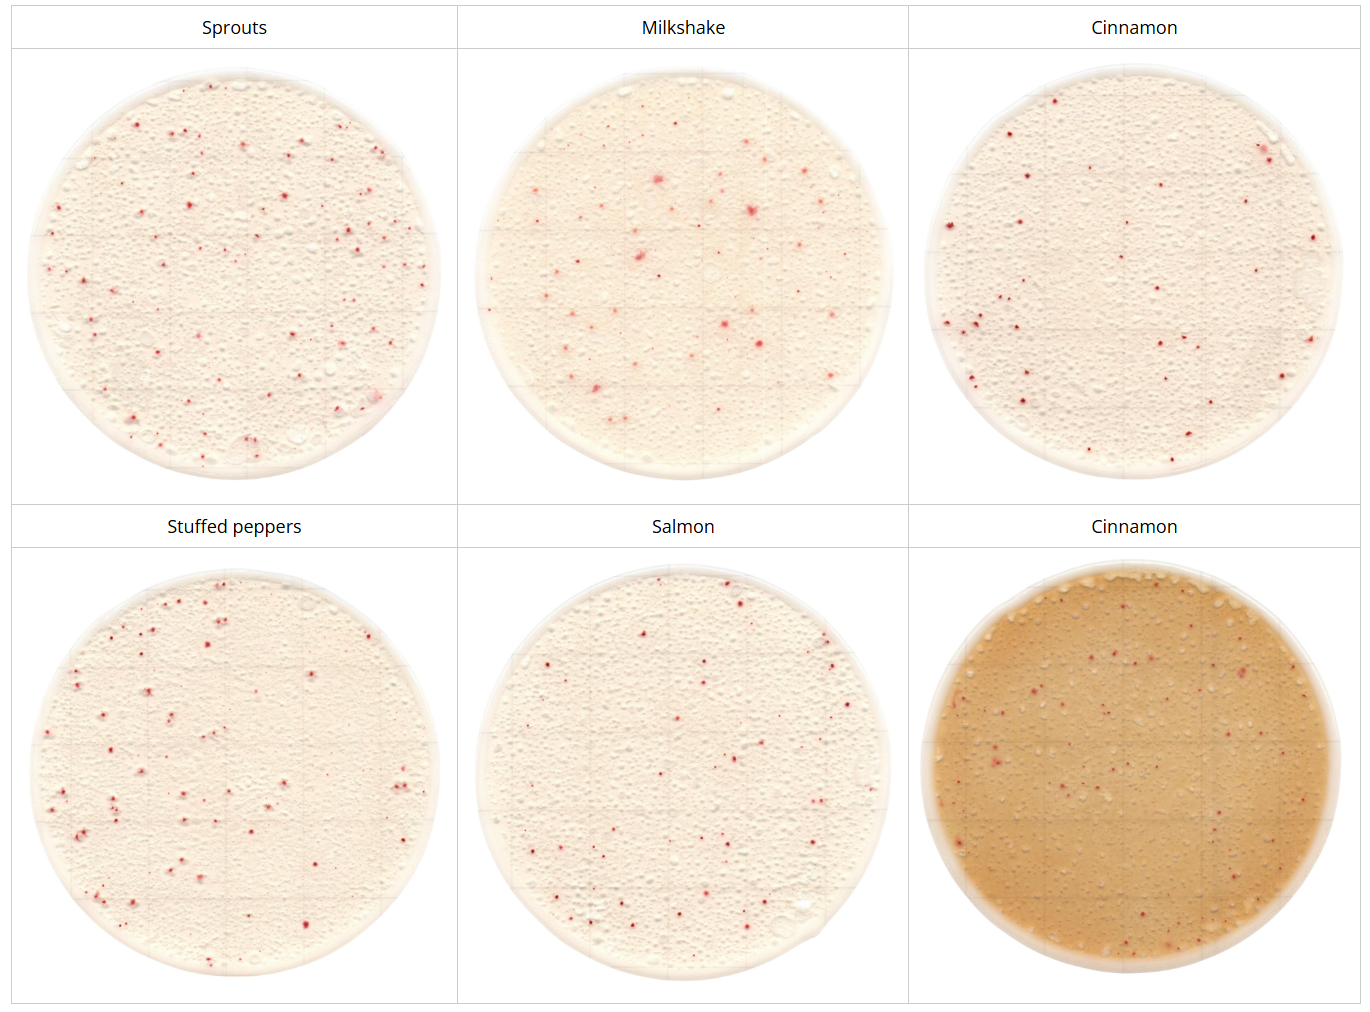

Description
Easy Plate AC-R is a specialized culture media designed for the detection, identification, and enumeration of aerobic bacteria. This ready-to-use plate contains a chemical indicator that facilitates the development of easily distinguishable red-colored colonies, enabling straightforward identification and counting of aerobic bacteria within 24±1 hours. The test kit is available in packages containing 100 tests, divided into four separate bags, each holding 25 tests. When stored unopened at a temperature range of 2-8℃, Easy Plate AC-R maintains its efficacy for up to 12 months.
Features
1.Easy to distinguish bright-coloured colonies
- Identifying is simpler in comparison to agar count media due to the colour change, making it unnecessary to confirm the presence or absence of air bubbles or the size of colonies.
- The use of Easy Plate only requires a single sheet, whereas the surface plating method typically needs three or more plates.
| Easy Plate AC-R | Plate count agar |
![]() | ![]() |
2. Reducing the spreading of colonies of Bacillus spp.
Colonies of Bacillus spp. can easily spread on conventional agar media but spreading is controlled on Easy Plate.
| Easy Plate AC-R | Plate count agar |
![]() | ![]() |
3. High correlation with the plate count agar
High correlation with the plate count agar in various foods.
Colouring
Plate Count Interpretation
The appropriate number of colonies is between 1 and 250.
In certain cases, depending on the sample, colony growth may be insufficient after 24 hours.
If this occurs, please extend the incubation period beyond 24 hours as necessary.
Examples
Strains

Foods

- Incubation conditions: 35℃, 48 hours (Diluent: phosphate buffered saline)
- These colourings are for example only.
Product Specifications
| Packaging | 100 tests (25 tests x 4 bags) |
| Object Microorganism | Aerobic Bacteria |
| Incubation Times | 24 ± 1 hours In certain cases, depending on the sample, colony growth may be insufficient after 24 hours. If this occurs, please extend the incubation period beyond 24 hours as necessary. |
| Incubation Temperature | 35 ± 1℃ |
| Storage Condition (Unopened) | 2 – 8℃ |
| Storage Condition (After opened) | After opening the package, fold the open end of the package at least 2 times and tape it. Store in a refrigerator (2 to 8℃) and use within 3 months. |
| Shelf life | Shelf life 12 months after manufacturing date |
| Certification/Regulation | Certified by AOAC RI PTM |
For automated Easy Plate Colony Counting click here to view our Scanner!

Exportable Data and Reports for Regulatory Compliance


See how A3 technology finds what ATP technology can’t


